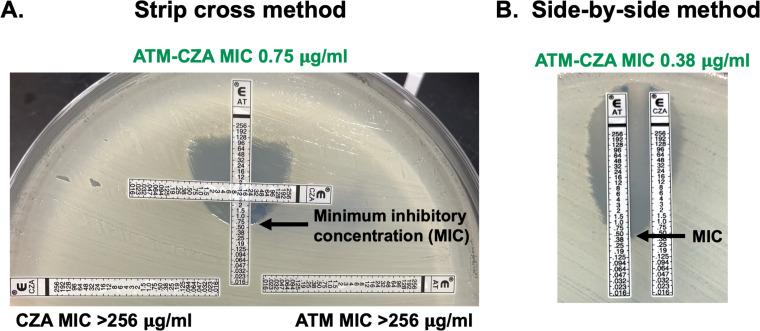
https://cdn.ncbi.nlm.nih.gov/pmc/blobs/1b31/11881574/d6f7b0652875/aac.01736-24.f001.jpg

评估两种梯度扩散试验以确定对氨曲南和头孢他啶-阿维巴坦联合用药的敏感性。
Evaluation of two gradient diffusion tests to determine susceptibility to aztreonam and ceftazidime-avibactam in combination.
作者信息
Khan Ayesha, Manuel Carmila, Maynard Richard, Humphries Romney M
机构信息
Pathology, Microbiology and Immunology, Vanderbilt University Medical Center, Nashville, Tennessee, USA.
出版信息
Antimicrob Agents Chemother. 2025 Mar 5;69(3):e0173624. doi: 10.1128/aac.01736-24. Epub 2025 Feb 7.
The combination of aztreonam and ceftazidime-avibactam (ATM-CZA) is a last resort regimen against recalcitrant infections caused by metallo-β-lactamase (MBL)-producing organisms. Susceptibility testing is warranted due to emerging resistance to the combination, but there are no widely implemented methods for use in clinical laboratories. Here, we used a cohort of 100 Enterobacterales, and strains, including 68 MBL producers, to evaluate the performance of two ETEST strip-based synergy testing methods: the side-by-side (SS) method with an ATM ETEST placed next to a CZA ETEST (10 mm apart) and the strip cross (SX) method with a CZA ETEST placed perpendicularly on top of the ATM ETEST (at the 8 µg/mL mark). By reference broth microdilution (BMD), 89.1% (41/46) of the Enterobacterales, 15% (3/20) of the , and 97.1% (33/34) of the isolates tested susceptible to the ATM-CZA combination. The SS method yielded 72% categorical agreement with BMD and 28 major errors (ME, 36.4%). Initial testing with the SX method yielded three ME , of which one was resolved upon repeat testing, yielding a final categorical agreement of 98% with BMD with two ME (2.6%). The SX method also yielded 100% reproducibility across three brands of Mueller Hinton agar (BD, Hardy, Remel). Our study demonstrates that the SX method is accurate, precise, and feasible for clinical laboratories to perform ATM-CZA susceptibility testing to guide use of the combination for treatment of multidrug-resistant gram-negative pathogens.
氨曲南与头孢他啶-阿维巴坦(ATM-CZA)联合用药是针对由产金属β-内酰胺酶(MBL)的微生物引起的顽固性感染的一种最后手段治疗方案。由于对该联合用药出现了耐药性,因此有必要进行药敏试验,但目前尚无广泛应用于临床实验室的方法。在此,我们使用了一组100株肠杆菌科细菌菌株,其中包括68株产MBL菌株,以评估两种基于ETEST试纸条的协同试验方法的性能:并排(SS)法,即将一条氨曲南ETEST试纸条与一条头孢他啶-阿维巴坦ETEST试纸条并排放置(相距10毫米);试纸条交叉(SX)法,即将一条头孢他啶-阿维巴坦ETEST试纸条垂直放置在氨曲南ETEST试纸条上方(在8μg/mL标记处)。通过参考肉汤微量稀释法(BMD),89.1%(41/46)的肠杆菌科细菌菌株、15%(3/20)的其他菌株以及97.1%(33/34)的分离株对ATM-CZA联合用药敏感。SS法与BMD的分类一致性为72%,有28个主要错误(ME,36.4%)。用SX法进行的初始试验产生了3个ME,其中1个在重复试验时得到解决,最终与BMD的分类一致性为98%,有2个ME(2.6%)。SX法在三种品牌的穆勒-欣顿琼脂(BD、Hardy、Remel)上的重复性也达到了100%。我们的研究表明,SX法准确、精确且可行,临床实验室可采用该方法进行ATM-CZA药敏试验,以指导该联合用药用于治疗多重耐药革兰氏阴性病原体。